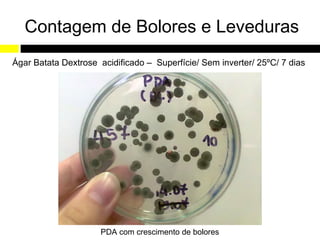
Contagem de Bolores e Leveduras
Ágar Batata Dextrose acidificado – Superfície/ Sem inverter/ 25ºC/ 7 dias




                      PDA com crescimento de bolores
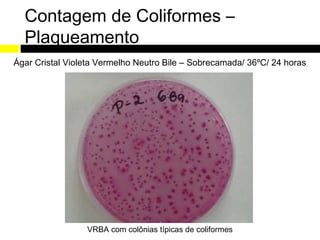
Contagem de Coliformes –
  Plaqueamento
Ágar Cristal Violeta Vermelho Neutro Bile – Sobrecamada/ 36ºC/ 24 horas




                 VRBA com colônias típicas de coliformes
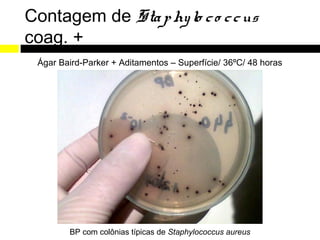
Contagem de Sta p hy lo c o c c us
coag. +
 Ágar Baird-Parker + Aditamentos – Superfície/ 36ºC/ 48 horas




        BP com colônias típicas de Staphylococcus aureus
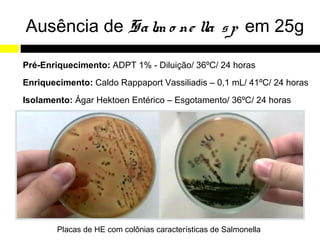
Ausência de Sa lm o ne lla s p em 25g

Pré-Enriquecimento: ADPT 1% - Diluição/ 36ºC/ 24 horas
Enriquecimento: Caldo Rappaport Vassiliadis – 0,1 mL/ 41ºC/ 24 horas
Isolamento: Ágar Hektoen Entérico – Esgotamento/ 36ºC/ 24 horas




        Placas de HE com colônias características de Salmonella
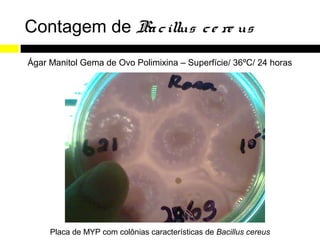
Contagem de Ba c illus c e re us
Ágar Manitol Gema de Ovo Polimixina – Superfície/ 36ºC/ 24 horas




     Placa de MYP com colônias características de Bacillus cereus

Este relatório de estágio descreve as atividades realizadas no Laboratório de Análises Microbiológicas e Físico-Químicas de Alimentos e Água (LAMAG) da UTFPR entre maio e novembro de 2011. O estágio teve como objetivos gerais desenvolver habilidades do estudante e ampliar seu conhecimento na área, e objetivos específicos como receber amostras, preparar meios de cultura, realizar análises microbiológicas e físico-químicas, e limpar equipamentos.